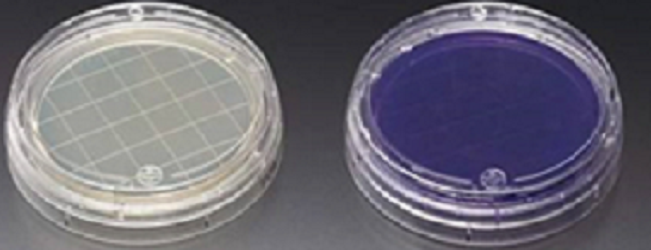
KP-N-NS细胞专用培养基

KP-N-NS细胞专用培养基
KP-N-NS cell-specific medium
询价
125ml
起订
浙江 更新日期:2026-04-05
产品详情:
- 中文名称:
- KP-N-NS细胞专用培养基
- 英文名称:
- KP-N-NS cell-specific medium
- 产品类别:
- 培养基
公司简介
宁波明舟生物科技有限公司是一家专注于细胞、微生物、菌株和分子生物资源开发、生物医学科研一站式服务的高新技术企业,同时代理ATCC原装进口细胞及菌株、Sciencell原代细胞。
团队以卓越的服务品质,专业安全的技术服务实力,构建了国内一流的生物资源生产和服务平台,以及国内体系完善的生物资源保藏中心(细胞和菌株)。 公司成立以来,经过不懈的努力与发展,已具有一定的规模与实力。目前拥有一家整体万级局部百级的GMP生产车间及完善的生物学实验室,现已建立一套严格的实验技术操作规范和质量控制体系(已通过ISO9001认证),两大细胞资源库(肿瘤细胞库和原代细胞库)、微生物菌种保藏中心,六大技术服务平台(分子生物学平台、细胞生物学平台、病毒包装平台、蛋白与抗体技术平台、检测平台与病理平台),保藏的生物资源达十余万种。生物科研实力雄厚,始终坚持以人为本,建立了一套严格完善人才的选拔机制,满足业务的发展需要。现拥有一支经验丰富、富有创新的跨学科技术团队。
| 成立日期 | (7年) |
| 注册资本 | 100.000000万人民币 |
| 员工人数 | 10-50人 |
| 年营业额 | ¥ 500万-1000万 |
| 经营模式 | 贸易 |
| 主营行业 | 生化试剂,细胞培养 |
KP-N-NS细胞专用培养基相关厂家报价 更多
-

- KP-N-NS细胞专用培养基
- 上海雅吉生物科技有限公司 VIP
- 2026-04-11
- ¥800
-

- KP-N-NS Cells(赠送Str鉴定报告)|人肾上腺神经母细胞瘤细胞
- 上海冠导生物工程有限公司 VIP
- 2026-04-11
- 询价
-

- KP-N-NS细胞:人肾上腺神经母细胞瘤细胞系
- 上海宾穗生物科技有限公司 VIP
- 2026-04-11
- 询价
-

- KP-N-NS细胞:人肾上腺神经母细胞瘤细胞
- 上海弘顺生物科技有限公司 VIP
- 2026-04-11
- 询价